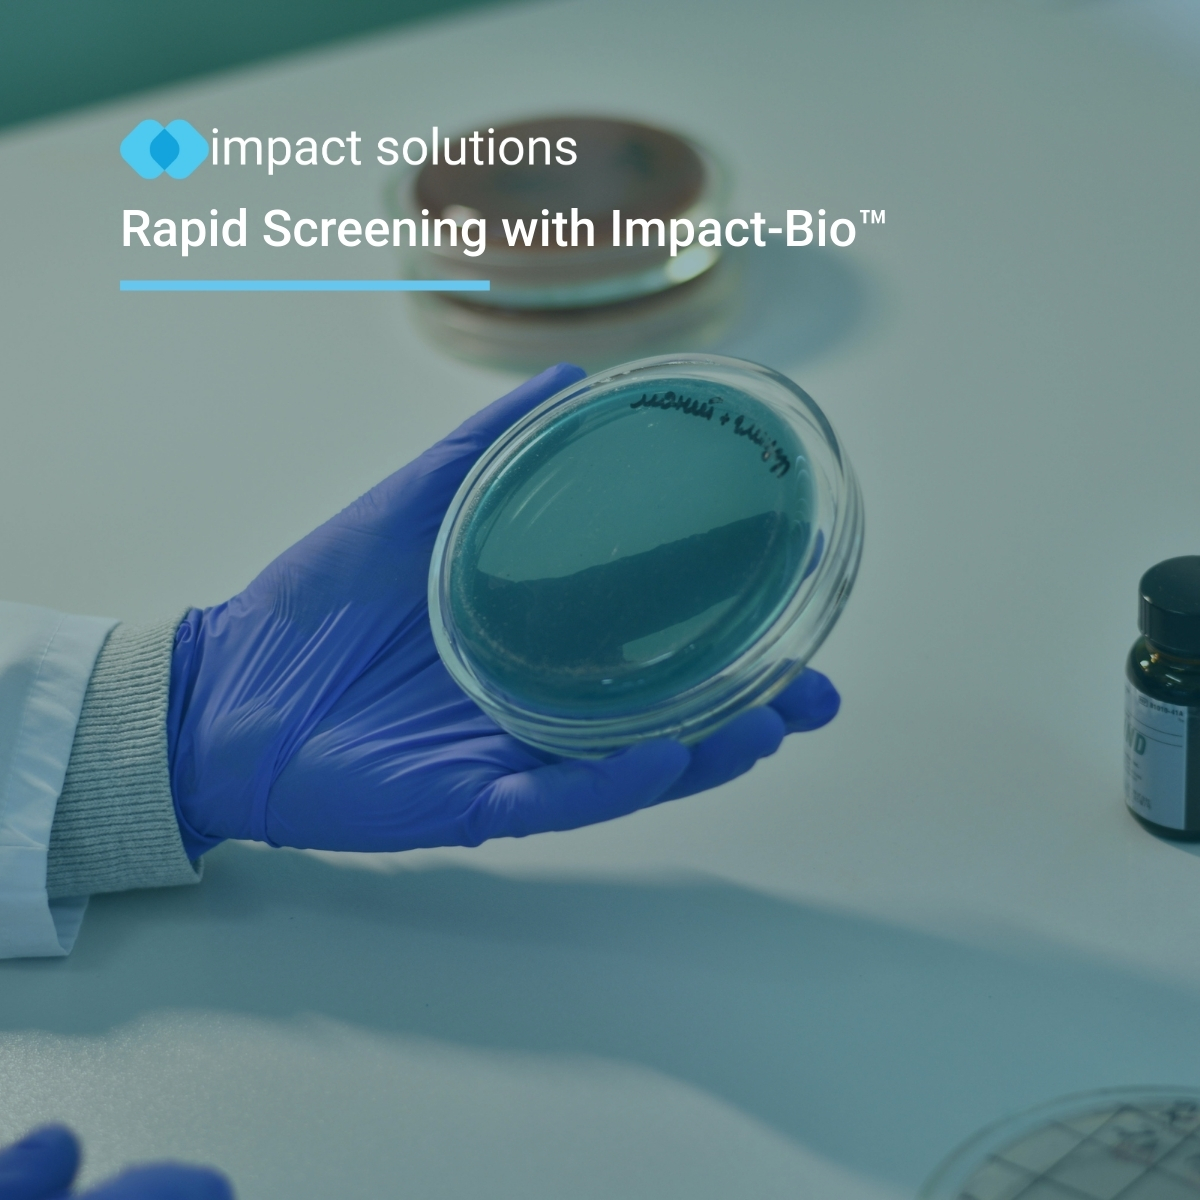
Impact Solutions tweet media

Microplastics often form when plastics fragment rather than biodegrade.
Breaking apart is not the same as biological breakdown.
Learn how fragmentation contributes to microplastic pollution in our latest blog.
Read more: impact-solutions.co.uk/microplastics-…

English